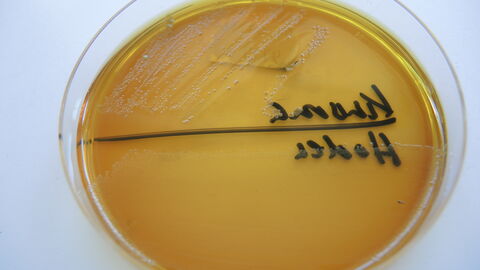
Salmonellennachweis aus Organen eines Wildschweins Petrischale mit Salmonellennachweis aus Organen eines Wildschweins

- Was sind Bakterien und Pilze?
- Auf welche bakteriellen Krankheitserreger wird bei uns untersucht?
- Welche Nachweismethoden werden angewandt und wie erfolgt die Bakterien-Identifizierung?
- Was ist eine in-vitro-Resistenzprüfung?
- Was versteht man unter einem Hemmstofftest?
- Was versteht man unter Akkreditierung?
- Leistungsspektrum (sortiert nach Prüfmethoden)
Schwerpunkte unserer Arbeit
- Bakterien und Pilze als Krankheitserreger von Tieren
- Untersuchungen auf Tierseuchenerreger
- Untersuchungen auf von Tieren auf den Menschen übertragbare Krankheiten (Zoonoseerreger)
- Aerobe, mikroaerophile und anaerobe Untersuchung von Pharmaka und Medizinprodukten (Chargen- und Sterilkontrollen)
- Untersuchung von Viertelgemelksproben im Rahmen der Eutergesundheit (Mastitisprophylaxe u. -therapie)
- Durchführung von Resistenztests zur Abgabe von Therapieempfehlungen (Antibiogramme)
- Untersuchungen für Gesundheitszeugnisse oder Unverdächtigkeitsbescheinigungen (bspw. Reisetauglichkeit bei Tauben, Zuchttauglichkeit für Hengste, Stuten, Zuchteber u. –bullen, Paratuberkulose)